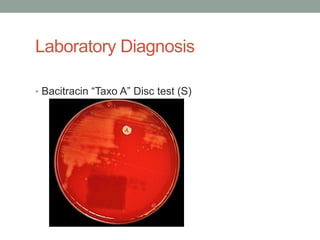
Laboratory Diagnosis

• Bacitracin “Taxo A” Disc test (S)

The document discusses laboratory diagnosis of Staphylococcus and Streptococcus bacteria. Key tests include gram stain, catalase test, coagulase test, mannitol salt agar, and novobiocin disc test to differentiate medically important staphylococcal species. For streptococci, hemolytic patterns on blood agar, optochin and bacitracin disc tests are used. Common pathogens include S. aureus, S. epidermidis, S. saprophyticus, S. pyogenes, S. agalactiae. Diseases range from skin infections to bacteremia, with S. aureus a major cause of infections like osteomyelitis, pneumonia and infect